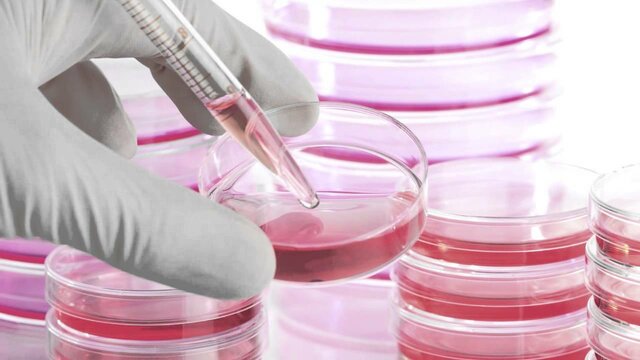
Terapia con células madre

-
 Es difícil decir exactamente cuándo las vacunas comenzaron a convertirse en una práctica aceptada. El camino para convencer de la utilidad de las vacunas no fue fácil, y nunca ha estado libre de detractores. Comenzó con el intento de Edward Jenner en 1796 de combatir el virus de la viruela con inoculaciones (inyección de una pequeña cantidad del virus).
Es difícil decir exactamente cuándo las vacunas comenzaron a convertirse en una práctica aceptada. El camino para convencer de la utilidad de las vacunas no fue fácil, y nunca ha estado libre de detractores. Comenzó con el intento de Edward Jenner en 1796 de combatir el virus de la viruela con inoculaciones (inyección de una pequeña cantidad del virus). -
Creada por Alessandro Volta, en 1800, esta tenía la capacidad de convertir la energía química en energía eléctrica.
-
En 1871 se inventó el teléfono, gracias a Antonio Meucci
-
 En 1879, Thomas Alba Edison, inventó la bombilla es uno de los inventos que mayor importancia ha tenido para el progreso de la civilización. Antes de la llegada de este invento, el hombre solo podía alumbrarse mediante el fuego, las velas o las lámparas de aceite.
En 1879, Thomas Alba Edison, inventó la bombilla es uno de los inventos que mayor importancia ha tenido para el progreso de la civilización. Antes de la llegada de este invento, el hombre solo podía alumbrarse mediante el fuego, las velas o las lámparas de aceite. -
En 1885, Carl Benz creó El Benz Patent-Motorwagen ("coche a motor patentado Benz", traducido de la lengua alemana) es un modelo de automóvil construido por Carl Benz en 1885, considerado como el primer vehículo de la historia diseñado para ser impulsado por un motor de combustión interna. El coste inicial de su fabricación en 1885 fue de 600 marcos de oro alemanes,
-
Alexander Fleming,con el uso de la penicilina en la década de 1940 se inició la era de los antibióticos, y este hito ha sido reconocido como uno de los mayores avances de la medicina terapéutica. El descubrimiento de la penicilina y el reconocimiento inicial de su potencial terapéutico ocurrió en el Reino Unido.
-
Aunque parezca increíble, el primer trasplante de órgano data solo de 1957. En Boston, EE. UU., el Dr. David Hume y el Dr. Joseph Murray realizaron el primer trasplante de riñón con éxito en diciembre de 1954. Antes de este, se habían realizado muchos intentos en la historia, pero es el primer caso en que el paciente sobrevivió a la cirugía.
-
Las células madre tienen la capacidad de reprogramarse en cualquier tipo de célula humana, incluso después de haber estado inactivas. El potencial de estas células se descubrió a fines de la década de 1970, cuando los investigadores encontraron células madre dentro de la sangre del cordón umbilical humano. Desde entonces, la terapia con células madre se ha utilizado para tratar la leucemia y otros trastornos de la sangre, y en los trasplantes de médula ósea.
-
 La IA (Artificial Intelligence) tiene multitud de aplicaciones en el sector de la salud. Desde el uso del machine learning para hacer diagnósticos preliminares, hasta el seguimiento de pacientes. De hecho, la inteligencia artificial está siendo una de las protagonistas en la lucha contra el Covid-19, desde el seguimiento de casos, hasta la búsqueda de un tratamiento eficaz.
La IA (Artificial Intelligence) tiene multitud de aplicaciones en el sector de la salud. Desde el uso del machine learning para hacer diagnósticos preliminares, hasta el seguimiento de pacientes. De hecho, la inteligencia artificial está siendo una de las protagonistas en la lucha contra el Covid-19, desde el seguimiento de casos, hasta la búsqueda de un tratamiento eficaz.
A list shows items. A timeline shows sequence.
Use Timetoast to make dates, milestones, and turning points easier to understand in a clear visual format. Timetoast is a timeline maker for work, school, research, and stories.